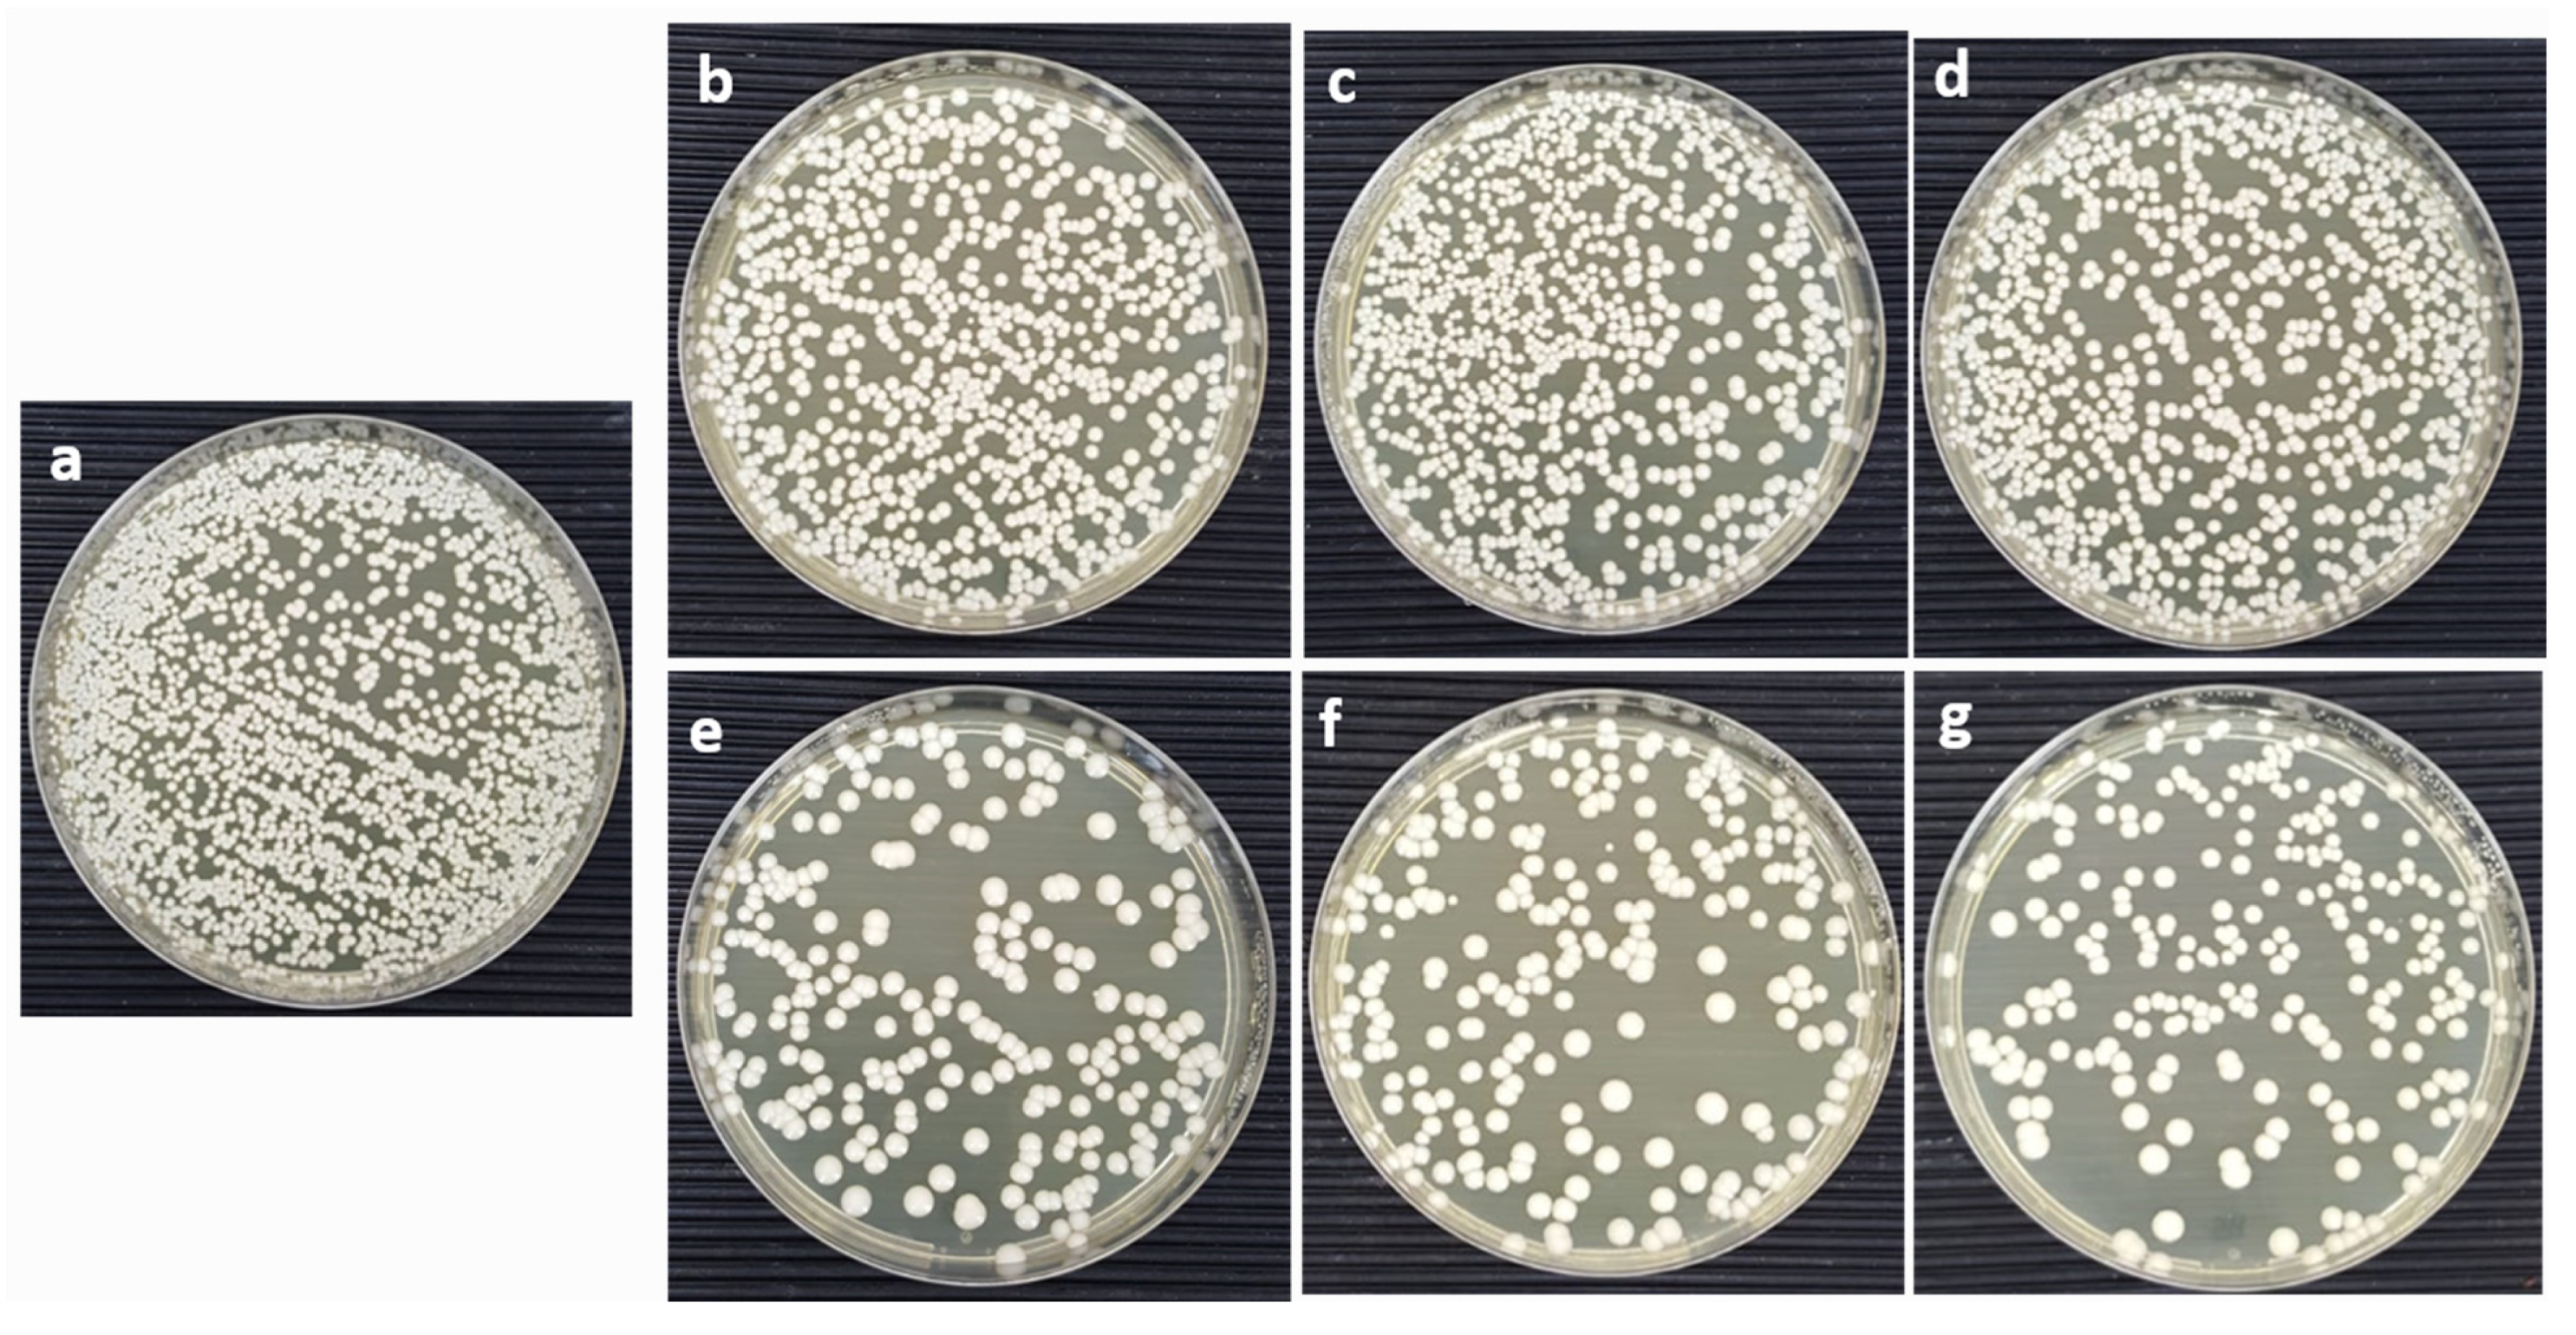

Pr3+ Ion-Substituted Ni-Co Nano-Spinel Ferrites: Their Synthesis, Characterization, and Biocompatibility for Colorectal Cancer and Candidaemia
Abstract
:1. Introduction
2. Results and Discussion
2.1. Microstructure and Morphology
2.2. Nitrogen Physisorption
2.3. Antifungal Activity
2.4. Morphogenesis Study Using SEM
2.5. Effect of CoNiPr (x ≤ 0.10) NSFs on Cancer Cell Viability
2.6. Disintegration of Cancer Cell DNA
3. Materials and Methods
3.1. Chemicals
3.2. Synthesis and Characterization
3.3. Antifungal Assay
3.4. Colony-Forming Unit (CFU)
3.5. Morphogenesis Studies Using SEM
3.6. In Vitro Evaluation of CoNiPr (x ≤ 0.10) NSFs)
3.7. Apoptotic Cell Death
4. Conclusions
Author Contributions
Funding
Institutional Review Board Statement
Informed Consent Statement
Data Availability Statement
Conflicts of Interest
References
- Rather, I.A.; Kim, B.-C.; Bajpai, V.K.; Park, Y.-H. Self-Medication and Antibiotic Resistance: Crisis, Current Challenges, and Prevention. Saudi J. Biol. Sci. 2017, 24, 808–812. [Google Scholar] [CrossRef] [PubMed]
- Manyi-Loh, C.; Mamphweli, S.; Meyer, E.; Okoh, A. Antibiotic Use in Agriculture and Its Consequential Resistance in Environmental Sources: Potential Public Health Implications. Molecules 2018, 23, 795. [Google Scholar] [CrossRef] [PubMed]
- Ksiezopolska, E.; Gabaldón, T. Evolutionary Emergence of Drug Resistance in Candida Opportunistic Pathogens. Genes 2018, 9, 461. [Google Scholar] [CrossRef] [PubMed]
- Kocarnik, J.M.; Compton, K.; Dean, F.E.; Fu, W.; Gaw, B.L.; Harvey, J.D.; Henrikson, H.J.; Lu, D.; Pennini, A.; Xu, R.; et al. Cancer Incidence, Mortality, Years of Life Lost, Years Lived with Disability, and Disability-Adjusted Life Years for 29 Cancer Groups from 2010 to 2019 a Systematic Analysis for the Global Burden of Disease Study 2019. JAMA Oncol. 2022, 8, 420–444. [Google Scholar] [CrossRef] [PubMed]
- Rabbani, A.; Haghniaz, R.; Khan, T.; Khan, R.; Khalid, A.; Naz, S.S.; Ul-Islam, M.; Vajhadin, F.; Wahid, F. Development of Bactericidal Spinel Ferrite Nanoparticles with Effective Biocompatibility for Potential Wound Healing Applications. RSC Adv. 2021, 11, 1773–1782. [Google Scholar] [CrossRef] [PubMed]
- Amiri, M.; Salavati-Niasari, M.; Akbari, A. Magnetic Nanocarriers: Evolution of Spinel Ferrites for Medical Applications. Adv. Colloid Interface Sci. 2019, 265, 29–44. [Google Scholar] [CrossRef]
- Almessiere, M.A.; Slimani, Y.; Rehman, S.; Khan, M.A.; Güngüneş, Ç.D.; Güner, S.; Shirsath, S.E.; Baykal, A. Magnetic properties, anticancer and antibacterial effectiveness of sonochemically produced Ce3+/Dy3+ co-activated Mn-Zn nanospinel ferrites. Arab. J. Chem. 2020, 30, 7403. [Google Scholar] [CrossRef]
- Li, X.; Gao, Y.; Li, H.; Majoral, J.-P.; Shi, X.; Pich, A. Smart and Bioinspired Systems for Overcoming Biological Barriers and Enhancing Disease Theranostics. Prog. Mater. Sci. 2023, 140, 101170. [Google Scholar] [CrossRef]
- Longo, R.; Gorrasi, G.; Guadagno, L. Electromagnetically Stimuli-Responsive Nanoparticles-Based Systems for Biomedical Applications: Recent Advances and Future Perspectives. Nanomaterials 2021, 11, 848. [Google Scholar] [CrossRef]
- Rodzinski, A.; Guduru, R.; Liang, P.; Hadjikhani, A.; Stewart, T.; Stimphil, E.; Runowicz, C.; Cote, R.; Altman, N.; Datar, R.; et al. Targeted and Controlled Anticancer Drug Delivery and Release with Magnetoelectric Nanoparticles. Sci. Rep. 2016, 6, 20867. [Google Scholar] [CrossRef]
- Dastjerd, O.D.; Shokrollahi, H.; Mirshekari, S. A review of synthesis, characterization, and magnetic properties of soft spinel ferrites. Inorg. Chem. Commun. 2023, 153, 110797. [Google Scholar] [CrossRef]
- Mazarío, E.; Cañete, M.; Herranz, F.; Sánchez-Marcos, J.; de la Fuente, J.M.; Herrasti, P.; Menéndez, N. Highly Efficient T2 Cobalt Ferrite Nanoparticles Vectorized for Internalization in Cancer Cells. Pharmaceuticals 2021, 14, 124. [Google Scholar] [CrossRef] [PubMed]
- Fiaz, S.; Ahmed, M.N.; ul Haq, I.; Shah, S.W.A.; Waseem, M. Green Synthesis of Cobalt Ferrite and Mn Doped Cobalt Ferrite Nanoparticles: Anticancer, Antidiabetic and Antibacterial Studies. J. Trace Elem. Med. Biol. 2023, 80, 127292. [Google Scholar] [CrossRef] [PubMed]
- Barani, M.; Rahdar, A.; Mukhtar, M.; Razzaq, S.; Qindeel, M.; Hosseini Olam, S.A.; Paiva-Santos, A.C.; Ajalli, N.; Sargazi, S.; Balakrishnan, D.; et al. Recent Application of Cobalt Ferrite Nanoparticles as a Theranostic Agent. Mater. Today Chem. 2022, 26, 101131. [Google Scholar] [CrossRef]
- Jermy, R.; Ravinayagam, V.; Alamoudi, W.; Almohazey, D.; Elanthikkal, S.; Dafalla, H.; Rehman, S.; Chandrasekar, G.; Baykal, A. Tuning PH Sensitive Chitosan and Cisplatin over Spinel Ferrite/Silica Nanocomposite for Anticancer Activity in MCF-7 Cell Line. J. Drug Deliv. Sci. Technol. 2020, 57, 101711. [Google Scholar] [CrossRef]
- Tatarchuk, T.; Bououdina, M.; Judith Vijaya, J.; John Kennedy, L. Spinel Ferrite Nanoparticles: Synthesis, Crystal Structure, Properties, and Perspective Applications. In Nanophysics, Nanomaterials, Interface Studies, and Applications, Proceedings of the 4th International Conference Nanotechnology and Nanomaterials (NANO2016), Lviv, Ukraine, 24–27 August 2016; Springer: Berlin/Heidelberg, Germany, 2017; Volume 195. [Google Scholar]
- Sertkol, M.; Slimani, Y.; Almessiere, M.A.; Sozeri, H.; Jermy, R.; Manikandan, A.; Shirsath, S.E.; UI-Hamid, A.; Baykal, A. Sonochemical Synthesis of Mn0.5Zn0.5ErxDyxFe2−2xO4 (x ≤ 0.1) Spinel Nanoferrites: Magnetic and Textural Investigation. J. Mol. Struct. 2022, 1258, 132680. [Google Scholar] [CrossRef]
- Li, J.; Yousaf, M.; Hayat, Q.; Akbar, M.; Noor, A.; Shah, M.A.K.Y.; Qi, F.; Lu, Y. Effect of Rare Earth Nd3+ Doping Contents on Physical, Structural, and Magnetic Properties of Co–Ni Spinel Ferrite Nanoparticles. J. Rare Earths 2022. [Google Scholar] [CrossRef]
- Farid, M.T.; Ahmad, I.; Kanwal, M.; Murtaza, G.; Ali, I.; Khan, S.A. The Role of Praseodymium Substituted Ions on Electrical and Magnetic Properties of Mg Spinel Ferrites. J. Magn. Magn. Mater. 2017, 428, 136–143. [Google Scholar] [CrossRef]
- Lakshmiprasanna, H.R.; Jagadeesha Angadi, V.; Rajesh Babu, B.; Pasha, M.; Manjunatha, K.; Matteppanavar, S. Effect of Pr3+-Doping on the Structural, Elastic and Magnetic Properties of Mn–Zn Ferrite Nanoparticles Prepared by Solution Combustion Synthesis Method. Chem. Data Collect. 2019, 24, 100273. [Google Scholar] [CrossRef]
- Zhou, X.; Wang, J.; Yao, D. Effect of Rare Earth Doping on Magnetic and Dielectric Properties of NiZnMn Ferrites. J. Alloys Compd. 2023, 935, 167777. [Google Scholar] [CrossRef]
- Pervaiz, E.; Gul, I.H. Influence of Rare Earth (Gd3+) on Structural, Gigahertz Dielectric and Magnetic Studies of Cobalt Ferrite. J. Phys. Conf. Ser. 2013, 439, 012015. [Google Scholar] [CrossRef]
- Simonescu, C.M.; Tătăruş, A.; Culiţă, D.C.; Stănică, N.; Butoi, B.; Kuncser, A. Facile Synthesis of Cobalt Ferrite (CoFe2O4) Nanoparticles in the Presence of Sodium Bis (2-Ethyl-Hexyl) Sulfosuccinate and Their Application in Dyes Removal from Single and Binary Aqueous Solutions. Nanomaterials 2021, 11, 3128. [Google Scholar] [CrossRef] [PubMed]
- Alfareed, T.M.; Slimani, Y.; Almessiere, M.A.; Nawaz, M.; Khan, F.A.; Baykal, A.; Al-Suhaimi, E.A. Biocompatibility and Colorectal Anti-Cancer Activity Study of Nanosized BaTiO3 Coated Spinel Ferrites. Sci. Rep. 2022, 12, 14127. [Google Scholar] [CrossRef]
- Ansari, M.A.; Akhtar, S.; Rauf, M.A.; Alomary, M.N.; Alyahya, S.; Alghamdi, S.; Almessiere, M.A.; Baykal, A.; Khan, F.; Adil, S.F.; et al. Sol–Gel Synthesis of Dy-Substituted Ni0.4cu0.2zn0.4 (Fe2−xdyx)O4 Nano Spinel Ferrites and Evaluation of Their Antibacterial, Antifungal, Antibiofilm and Anticancer Potentialities for Biomedical Application. Int. J. Nanomed. 2021, 16, 5633–5650. [Google Scholar] [CrossRef] [PubMed]
- Ansari, M.A.; Baykal, A.; Asiri, S.; Rehman, S. Synthesis and Characterization of Antibacterial Activity of Spinel Chromium-Substituted Copper Ferrite Nanoparticles for Biomedical Application. J. Inorg. Organomet. Polym. Mater. 2018, 28, 2316–2327. [Google Scholar] [CrossRef]
- Barathiraja, C.; Manikandan, A.; Uduman Mohideen, A.M.; Jayasree, S.; Antony, S.A. Magnetically Recyclable Spinel MnxNi1−xFe2O4 (X = 0.0–0.5) Nano-Photocatalysts: Structural, Morphological and Opto-Magnetic Properties. J. Supercond. Nov. Magn. 2016, 29, 477–486. [Google Scholar] [CrossRef]
- Ameen, F. Green Synthesis Spinel Ferrite Nanosheets and Their Cytotoxicity and Antibacterial Activity. Biomass Convers. Biorefin. 2022. [Google Scholar] [CrossRef]
- Sanpo, N.; Wen, C.; Berndt, C.C.; Wang, J. Antibacterial Properties of Spinel Ferrite Nanoparticles. In Microbial Pathogens and Strategies for Combating Them: Science, Technology and Education; Formatex Research Center: Badajoz, Spain, 2013. [Google Scholar]
- El-Sayed, E.S.R.; Abdelhakim, H.K.; Zakaria, Z. Extracellular Biosynthesis of Cobalt Ferrite Nanoparticles by Monascus Purpureus and Their Antioxidant, Anticancer and Antimicrobial Activities: Yield Enhancement by Gamma Irradiation. Materials Sci. Eng. C 2020, 107, 110318. [Google Scholar] [CrossRef]
- Kefeni, K.K.; Msagati, T.A.M.; Nkambule, T.T.I.; Mamba, B.B. Spinel Ferrite Nanoparticles and Nanocomposites for Biomedical Applications and Their Toxicity. Mater. Sci. Eng. C 2020, 107, 110314. [Google Scholar] [CrossRef]
- Jose, J.; Kumar, R.; Harilal, S.; Mathew, G.E.; Parambi, D.G.T.; Prabhu, A.; Uddin, M.S.; Aleya, L.; Kim, H.; Mathew, B. Magnetic Nanoparticles for Hyperthermia in Cancer Treatment: An Emerging Tool. Environ. Sci. Pollut. Res. 2020, 27, 19214–19225. [Google Scholar] [CrossRef]
- Suleman, M.; Riaz, S. 3D in Silico Study of Magnetic Fluid Hyperthermia of Breast Tumor Using Fe3O4 Magnetic Nanoparticles. J. Therm. Biol. 2020, 91, 102635. [Google Scholar] [CrossRef] [PubMed]
- Rajan, A.; Sahu, N.K. Review on Magnetic Nanoparticle-Mediated Hyperthermia for Cancer Therapy. J. Nanoparticle Res. 2020, 22, 319. [Google Scholar] [CrossRef]
- Garanina, A.S.; Naumenko, V.A.; Nikitin, A.A.; Myrovali, E.; Petukhova, A.Y.; Klimyuk, S.V.; Nalench, Y.A.; Ilyasov, A.R.; Vodopyanov, S.S.; Erofeev, A.S.; et al. Temperature-Controlled Magnetic Nanoparticles Hyperthermia Inhibits Primary Tumor Growth and Metastases Dissemination. Nanomedicine 2020, 25, 102171. [Google Scholar] [CrossRef] [PubMed]
- Andrade, R.G.D.; Veloso, S.R.S.; Castanheira, E.M.S. Shape Anisotropic Iron Oxide-Based Magnetic Nanoparticles: Synthesis and Biomedical Applications. Int. J. Mol. Sci. 2020, 21, 2455. [Google Scholar] [CrossRef]
- Salmani, M.M.; Hashemian, M.; Yekta, H.J.; Nejad, M.G.; Saber-Samandari, S.; Khandan, A. Synergic Effects of Magnetic Nanoparticles on Hyperthermia-Based Therapy and Controlled Drug Delivery for Bone Substitute Application. J. Supercond. Nov. Magn. 2020, 33, 2809–2820. [Google Scholar] [CrossRef]
- Fan, H.; Li, B.; Shi, Z.; Zhao, L.; Wang, K.; Qiu, D. A Fibrous Morphology Silica-CoFe2O4 Nanocarrier for Anti-Cancer Drug Delivery. Ceram. Int. 2018, 44, 2345–2350. [Google Scholar] [CrossRef]
- Guo, H.; Wang, Z.; Du, Q.; Li, P.; Wang, Z.; Wang, A. Stimulated Phase-Shift Acoustic Nanodroplets Enhance Vancomycin Efficacy against Methicillin-Resistant Staphylococcus Aureus Biofilms. Int. J. Nanomed. 2017, 12, 4679–4690. [Google Scholar] [CrossRef]
- Bondaryk, M.; Staniszewska, M.; Zielińska, P.; Urbańczyk-Lipkowska, Z. Natural Antimicrobial Peptides as Inspiration for Design of a New Generation Antifungal Compounds. J. Fungi 2017, 3, 46. [Google Scholar] [CrossRef]
- Aldakheel, R.K.; Rehman, S.; Almessiere, M.A.; Khan, F.A.; Gondal, M.A.; Mostafa, A.; Baykal, A. Bactericidal and in Vitro Cytotoxicity of Moringa Oleifera Seed Extract and Its Elemental Analysis Using Laser-Induced Breakdown Spectroscopy. Pharmaceuticals 2020, 13, 193. [Google Scholar] [CrossRef]
- Khan, F.A.; Akhtar, S.; Almohazey, D.; Alomari, M.; Almofty, S.A. Extracts of Clove (Syzygium Aromaticum) Potentiate FMSP-Nanoparticles Induced Cell Death in MCF-7 Cells. Int. J. Biomater. 2018, 2018, 8479439. [Google Scholar] [CrossRef]
- Dekaliuk, M.; Pyrshev, K.; Demchenko, A. Visualization and Detection of Live and Apoptotic Cells with Fluorescent Carbon Nanoparticles. J. Nanobiotechnol. 2015, 13, 86. [Google Scholar] [CrossRef] [PubMed]

| x | BET Surface Area (m2/g) | Pore Volume (cm3/g) | Average Pore Size (nm) |
|---|---|---|---|
| 0.00 | 91 | 0.09 | 3.8 |
| 0.02 | 125 | 0.09 | 2.8 |
| 0.04 | 146 | 0.13 | 3.7 |
| 0.06 | 151 | 0.12 | 3.3 |
| 0.08 | 117 | 0.08 | 2.8 |
| CoNiPr | Particle Size (nm) | Polydispersity Index | Zeta Potential (mV) |
|---|---|---|---|
| x = 0.00 | 1327 | 0.58 | −6.13 |
| x = 0.08 | 1923 | 0.47 | −10.2 |
| Co0.5Ni0.5PrxFe2-xO4 (0.00 ≤ x ≤ 0.10) NSFs | HCT-11 (IC50) (µg/mL) |
|---|---|
| x = 0.00 | 63 ± 4.61 |
| x = 0.02 | 227 ± 7.91 |
| x = 0.04 | 57 ± 1.21 |
| x = 0.06 | 106 ± 2.41 |
| x = 0.08 | 46 ± 0.91 |
| x = 0.10 | 288 ± 8.21 |
Disclaimer/Publisher’s Note: The statements, opinions and data contained in all publications are solely those of the individual author(s) and contributor(s) and not of MDPI and/or the editor(s). MDPI and/or the editor(s) disclaim responsibility for any injury to people or property resulting from any ideas, methods, instructions or products referred to in the content. |
© 2023 by the authors. Licensee MDPI, Basel, Switzerland. This article is an open access article distributed under the terms and conditions of the Creative Commons Attribution (CC BY) license (https://creativecommons.org/licenses/by/4.0/).
Share and Cite
Rehman, S.; Jermy, B.R.; Rather, I.A.; Sabir, J.S.M.; Aljameel, S.S.; Almessiere, M.A.; Slimani, Y.; Khan, F.A.; Baykal, A. Pr3+ Ion-Substituted Ni-Co Nano-Spinel Ferrites: Their Synthesis, Characterization, and Biocompatibility for Colorectal Cancer and Candidaemia. Pharmaceuticals 2023, 16, 1494. https://doi.org/10.3390/ph16101494
Rehman S, Jermy BR, Rather IA, Sabir JSM, Aljameel SS, Almessiere MA, Slimani Y, Khan FA, Baykal A. Pr3+ Ion-Substituted Ni-Co Nano-Spinel Ferrites: Their Synthesis, Characterization, and Biocompatibility for Colorectal Cancer and Candidaemia. Pharmaceuticals. 2023; 16(10):1494. https://doi.org/10.3390/ph16101494
Chicago/Turabian StyleRehman, Suriya, Balasamy Rabindran Jermy, Irfan A. Rather, Jamal S. M. Sabir, Suhailah S. Aljameel, Munirah A. Almessiere, Yassine Slimani, Firdos A. Khan, and Abdulhadi Baykal. 2023. "Pr3+ Ion-Substituted Ni-Co Nano-Spinel Ferrites: Their Synthesis, Characterization, and Biocompatibility for Colorectal Cancer and Candidaemia" Pharmaceuticals 16, no. 10: 1494. https://doi.org/10.3390/ph16101494
APA StyleRehman, S., Jermy, B. R., Rather, I. A., Sabir, J. S. M., Aljameel, S. S., Almessiere, M. A., Slimani, Y., Khan, F. A., & Baykal, A. (2023). Pr3+ Ion-Substituted Ni-Co Nano-Spinel Ferrites: Their Synthesis, Characterization, and Biocompatibility for Colorectal Cancer and Candidaemia. Pharmaceuticals, 16(10), 1494. https://doi.org/10.3390/ph16101494

